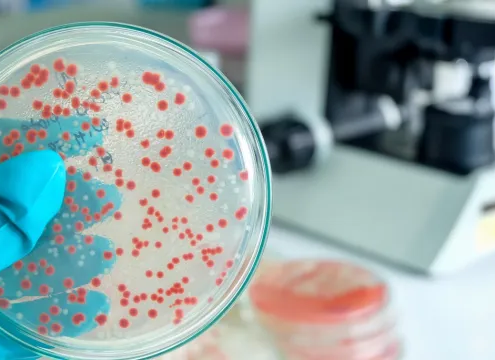

https://alphastrumenti.com/wp-content/uploads/2026/04/ART_1517.jpg
631
600
s6YbpV4uzUeY7BN3
http://alphastrumenti.com/wp-content/uploads/2017/08/logo-1-300x128.png
s6YbpV4uzUeY7BN32026-04-10 09:33:412026-04-13 09:36:36ALA – Nuovo lotto n. 202550810 (scadenza 08/2027)
https://alphastrumenti.com/wp-content/uploads/2026/04/ART_1517.jpg
631
600
s6YbpV4uzUeY7BN3
http://alphastrumenti.com/wp-content/uploads/2017/08/logo-1-300x128.png
s6YbpV4uzUeY7BN32026-04-10 09:33:412026-04-13 09:36:36ALA – Nuovo lotto n. 202550810 (scadenza 08/2027)ALPHA STRUMENTI
SHOPRichiedi InformazioniPer la Terapia Fotodinamica – PDT. Per la Crioterapia, UMP Berna. Per la dermatologia estetica, Dermaroller Germany. Per la fototerapia, Dr. Hoenle Germany.

Servizio Assistenza
Per informazioni commerciali ed amministrative
TEL: +39.0295738540
FAX: +39.0295518115
Informazioni Prodotti
Richieste di assistenza e dettaglio su i prodotti:
EMAIL: info@alphastrumenti.com
Alpha Strumenti opera da alcuni anni nel campo medico dermatologico con prodotti per la diagnostica, la dermatologia estetica e la crioterapia. Inoltre, Alpha strumenti, leader nella produzione di dispositivi medici per la terapia fotodinamica, ha recentemente introdotto con successo la PDT in odontoiatria per la cura di parodontiti e perimplantiti.
Area Shop
Consulta le ultime news
 https://alphastrumenti.com/wp-content/uploads/2026/04/ART_1517.jpg
631
600
s6YbpV4uzUeY7BN3
http://alphastrumenti.com/wp-content/uploads/2017/08/logo-1-300x128.png
s6YbpV4uzUeY7BN32026-04-10 09:33:412026-04-13 09:36:36ALA – Nuovo lotto n. 202550810 (scadenza 08/2027)
https://alphastrumenti.com/wp-content/uploads/2026/04/ART_1517.jpg
631
600
s6YbpV4uzUeY7BN3
http://alphastrumenti.com/wp-content/uploads/2017/08/logo-1-300x128.png
s6YbpV4uzUeY7BN32026-04-10 09:33:412026-04-13 09:36:36ALA – Nuovo lotto n. 202550810 (scadenza 08/2027) https://alphastrumenti.com/wp-content/uploads/2025/11/streptococco.webp
360
640
s6YbpV4uzUeY7BN3
http://alphastrumenti.com/wp-content/uploads/2017/08/logo-1-300x128.png
s6YbpV4uzUeY7BN32025-11-21 13:56:232025-11-21 13:56:23Efficacia dell’ Acido 5-aminolevulinico verso batteri e superbatteri
https://alphastrumenti.com/wp-content/uploads/2025/11/streptococco.webp
360
640
s6YbpV4uzUeY7BN3
http://alphastrumenti.com/wp-content/uploads/2017/08/logo-1-300x128.png
s6YbpV4uzUeY7BN32025-11-21 13:56:232025-11-21 13:56:23Efficacia dell’ Acido 5-aminolevulinico verso batteri e superbatteri https://alphastrumenti.com/wp-content/uploads/2025/10/foto-2.jpg
720
720
s6YbpV4uzUeY7BN3
http://alphastrumenti.com/wp-content/uploads/2017/08/logo-1-300x128.png
s6YbpV4uzUeY7BN32025-10-08 09:04:552025-10-08 09:04:55TL-07 Nuovo emettitore da banco per PDT
https://alphastrumenti.com/wp-content/uploads/2025/10/foto-2.jpg
720
720
s6YbpV4uzUeY7BN3
http://alphastrumenti.com/wp-content/uploads/2017/08/logo-1-300x128.png
s6YbpV4uzUeY7BN32025-10-08 09:04:552025-10-08 09:04:55TL-07 Nuovo emettitore da banco per PDT https://alphastrumenti.com/wp-content/uploads/2025/09/Terapia-Fotodinamica-scaled.jpg
2560
1786
s6YbpV4uzUeY7BN3
http://alphastrumenti.com/wp-content/uploads/2017/08/logo-1-300x128.png
s6YbpV4uzUeY7BN32025-09-04 07:28:422025-09-09 14:02:21Photodynamic Therapy (Terza Edizione)
https://alphastrumenti.com/wp-content/uploads/2025/09/Terapia-Fotodinamica-scaled.jpg
2560
1786
s6YbpV4uzUeY7BN3
http://alphastrumenti.com/wp-content/uploads/2017/08/logo-1-300x128.png
s6YbpV4uzUeY7BN32025-09-04 07:28:422025-09-09 14:02:21Photodynamic Therapy (Terza Edizione) https://alphastrumenti.com/wp-content/uploads/2025/03/picuture-1030x579-1.jpg
579
1030
s6YbpV4uzUeY7BN3
http://alphastrumenti.com/wp-content/uploads/2017/08/logo-1-300x128.png
s6YbpV4uzUeY7BN32025-03-03 15:20:232025-03-03 15:20:23Condilomi e crioterapia
https://alphastrumenti.com/wp-content/uploads/2025/03/picuture-1030x579-1.jpg
579
1030
s6YbpV4uzUeY7BN3
http://alphastrumenti.com/wp-content/uploads/2017/08/logo-1-300x128.png
s6YbpV4uzUeY7BN32025-03-03 15:20:232025-03-03 15:20:23Condilomi e crioterapia https://alphastrumenti.com/wp-content/uploads/2024/05/ART_1701-773x1030-1.jpg
1030
773
s6YbpV4uzUeY7BN3
http://alphastrumenti.com/wp-content/uploads/2017/08/logo-1-300x128.png
s6YbpV4uzUeY7BN32024-05-06 09:03:072024-05-08 13:35:31Red light therapy, i benefici per la pelle in un articolo di Vanity Fair
https://alphastrumenti.com/wp-content/uploads/2024/05/ART_1701-773x1030-1.jpg
1030
773
s6YbpV4uzUeY7BN3
http://alphastrumenti.com/wp-content/uploads/2017/08/logo-1-300x128.png
s6YbpV4uzUeY7BN32024-05-06 09:03:072024-05-08 13:35:31Red light therapy, i benefici per la pelle in un articolo di Vanity Fair https://alphastrumenti.com/wp-content/uploads/2021/09/ant.jpg
1000
1081
s6YbpV4uzUeY7BN3
http://alphastrumenti.com/wp-content/uploads/2017/08/logo-1-300x128.png
s6YbpV4uzUeY7BN32024-04-08 07:31:102024-04-08 10:22:09Hailey-Hailey. Le testimonianze di chi è stato trattato con PDT Alpha Strumenti.
https://alphastrumenti.com/wp-content/uploads/2021/09/ant.jpg
1000
1081
s6YbpV4uzUeY7BN3
http://alphastrumenti.com/wp-content/uploads/2017/08/logo-1-300x128.png
s6YbpV4uzUeY7BN32024-04-08 07:31:102024-04-08 10:22:09Hailey-Hailey. Le testimonianze di chi è stato trattato con PDT Alpha Strumenti. https://alphastrumenti.com/wp-content/uploads/2024/02/Senza-nome-1-e1709289256574.jpg
456
536
s6YbpV4uzUeY7BN3
http://alphastrumenti.com/wp-content/uploads/2017/08/logo-1-300x128.png
s6YbpV4uzUeY7BN32024-02-14 17:12:502024-03-01 10:34:25Viaggio nel modo della luce
https://alphastrumenti.com/wp-content/uploads/2024/02/Senza-nome-1-e1709289256574.jpg
456
536
s6YbpV4uzUeY7BN3
http://alphastrumenti.com/wp-content/uploads/2017/08/logo-1-300x128.png
s6YbpV4uzUeY7BN32024-02-14 17:12:502024-03-01 10:34:25Viaggio nel modo della luce https://alphastrumenti.com/wp-content/uploads/2024/01/foto1.png
515
885
s6YbpV4uzUeY7BN3
http://alphastrumenti.com/wp-content/uploads/2017/08/logo-1-300x128.png
s6YbpV4uzUeY7BN32024-01-22 13:53:092024-01-22 13:53:51Nuovo dermatoscopio DL-200
https://alphastrumenti.com/wp-content/uploads/2024/01/foto1.png
515
885
s6YbpV4uzUeY7BN3
http://alphastrumenti.com/wp-content/uploads/2017/08/logo-1-300x128.png
s6YbpV4uzUeY7BN32024-01-22 13:53:092024-01-22 13:53:51Nuovo dermatoscopio DL-200 https://alphastrumenti.com/wp-content/uploads/2022/10/IMG-20221001-WA0008-1.jpg
2048
1536
s6YbpV4uzUeY7BN3
http://alphastrumenti.com/wp-content/uploads/2017/08/logo-1-300x128.png
s6YbpV4uzUeY7BN32022-10-03 17:30:462022-10-04 08:10:18Premio alla Dott.ssa Tania Pierfelice al 36° congresso nazionale SIF
https://alphastrumenti.com/wp-content/uploads/2022/10/IMG-20221001-WA0008-1.jpg
2048
1536
s6YbpV4uzUeY7BN3
http://alphastrumenti.com/wp-content/uploads/2017/08/logo-1-300x128.png
s6YbpV4uzUeY7BN32022-10-03 17:30:462022-10-04 08:10:18Premio alla Dott.ssa Tania Pierfelice al 36° congresso nazionale SIF https://alphastrumenti.com/wp-content/uploads/2022/06/vlcsnap-2022-06-02-10h46m05s489.png
640
640
s6YbpV4uzUeY7BN3
http://alphastrumenti.com/wp-content/uploads/2017/08/logo-1-300x128.png
s6YbpV4uzUeY7BN32022-06-02 08:47:452022-06-02 08:48:23Terapia fotodinamica (PDT) per il trattamento dell’acne giovanile
https://alphastrumenti.com/wp-content/uploads/2022/06/vlcsnap-2022-06-02-10h46m05s489.png
640
640
s6YbpV4uzUeY7BN3
http://alphastrumenti.com/wp-content/uploads/2017/08/logo-1-300x128.png
s6YbpV4uzUeY7BN32022-06-02 08:47:452022-06-02 08:48:23Terapia fotodinamica (PDT) per il trattamento dell’acne giovanile https://alphastrumenti.com/wp-content/uploads/2022/03/1-s2.0-S1572100021X00051-cov150h.gif
150
113
s6YbpV4uzUeY7BN3
http://alphastrumenti.com/wp-content/uploads/2017/08/logo-1-300x128.png
s6YbpV4uzUeY7BN32022-03-16 10:59:132022-03-16 10:59:13Photodynamic therapy with 5 aminolaevulinic acid: a promising therapeutic option for the treatment of Hailey-Hailey Disease
https://alphastrumenti.com/wp-content/uploads/2022/03/1-s2.0-S1572100021X00051-cov150h.gif
150
113
s6YbpV4uzUeY7BN3
http://alphastrumenti.com/wp-content/uploads/2017/08/logo-1-300x128.png
s6YbpV4uzUeY7BN32022-03-16 10:59:132022-03-16 10:59:13Photodynamic therapy with 5 aminolaevulinic acid: a promising therapeutic option for the treatment of Hailey-Hailey Disease https://alphastrumenti.com/wp-content/uploads/2021/11/acne-prima-e-dopo-PDT.jpg
379
599
s6YbpV4uzUeY7BN3
http://alphastrumenti.com/wp-content/uploads/2017/08/logo-1-300x128.png
s6YbpV4uzUeY7BN32021-11-18 10:00:412021-11-18 10:00:41Acne, allarme antibiotico-resistenza.
https://alphastrumenti.com/wp-content/uploads/2021/11/acne-prima-e-dopo-PDT.jpg
379
599
s6YbpV4uzUeY7BN3
http://alphastrumenti.com/wp-content/uploads/2017/08/logo-1-300x128.png
s6YbpV4uzUeY7BN32021-11-18 10:00:412021-11-18 10:00:41Acne, allarme antibiotico-resistenza. https://alphastrumenti.com/wp-content/uploads/2021/11/ALPHA-INFO.jpg
1080
1080
s6YbpV4uzUeY7BN3
http://alphastrumenti.com/wp-content/uploads/2017/08/logo-1-300x128.png
s6YbpV4uzUeY7BN32021-11-18 09:56:482021-11-18 09:57:51Informativa contratto di licenza brevetto italiano
https://alphastrumenti.com/wp-content/uploads/2021/11/ALPHA-INFO.jpg
1080
1080
s6YbpV4uzUeY7BN3
http://alphastrumenti.com/wp-content/uploads/2017/08/logo-1-300x128.png
s6YbpV4uzUeY7BN32021-11-18 09:56:482021-11-18 09:57:51Informativa contratto di licenza brevetto italiano https://alphastrumenti.com/wp-content/uploads/2021/10/ColgateTalks_logo.jpg
848
1280
s6YbpV4uzUeY7BN3
http://alphastrumenti.com/wp-content/uploads/2017/08/logo-1-300x128.png
s6YbpV4uzUeY7BN32021-10-11 08:36:372021-10-11 08:39:51**Free webinars elmex e meridol – In omaggio 2 corsi FAD: 10+15 crediti ECM**
https://alphastrumenti.com/wp-content/uploads/2021/10/ColgateTalks_logo.jpg
848
1280
s6YbpV4uzUeY7BN3
http://alphastrumenti.com/wp-content/uploads/2017/08/logo-1-300x128.png
s6YbpV4uzUeY7BN32021-10-11 08:36:372021-10-11 08:39:51**Free webinars elmex e meridol – In omaggio 2 corsi FAD: 10+15 crediti ECM** https://alphastrumenti.com/wp-content/uploads/2021/10/Screenshot-20240412095723.png
575
893
s6YbpV4uzUeY7BN3
http://alphastrumenti.com/wp-content/uploads/2017/08/logo-1-300x128.png
s6YbpV4uzUeY7BN32021-10-01 10:06:192024-04-12 07:58:23La PDT nella pratica quotidiana del dermatologo. Intervista al Dr. Mauro Berta – Dermatologo, Roma.
https://alphastrumenti.com/wp-content/uploads/2021/10/Screenshot-20240412095723.png
575
893
s6YbpV4uzUeY7BN3
http://alphastrumenti.com/wp-content/uploads/2017/08/logo-1-300x128.png
s6YbpV4uzUeY7BN32021-10-01 10:06:192024-04-12 07:58:23La PDT nella pratica quotidiana del dermatologo. Intervista al Dr. Mauro Berta – Dermatologo, Roma. https://alphastrumenti.com/wp-content/uploads/2021/09/spallanzani-informa-cop-min.png
927
1656
s6YbpV4uzUeY7BN3
http://alphastrumenti.com/wp-content/uploads/2017/08/logo-1-300x128.png
s6YbpV4uzUeY7BN32021-09-03 12:21:112021-09-04 12:58:25Fotodinamica con Alagel nelle malattie dermatologiche rare
https://alphastrumenti.com/wp-content/uploads/2021/09/spallanzani-informa-cop-min.png
927
1656
s6YbpV4uzUeY7BN3
http://alphastrumenti.com/wp-content/uploads/2017/08/logo-1-300x128.png
s6YbpV4uzUeY7BN32021-09-03 12:21:112021-09-04 12:58:25Fotodinamica con Alagel nelle malattie dermatologiche rare https://alphastrumenti.com/wp-content/uploads/2021/06/libro-terapia-fotodinamica.jpg
214
342
s6YbpV4uzUeY7BN3
http://alphastrumenti.com/wp-content/uploads/2017/08/logo-1-300x128.png
s6YbpV4uzUeY7BN32021-06-16 14:05:282021-06-16 14:06:56Malattie dermatologiche rare: i benefici terapeutici della luce
https://alphastrumenti.com/wp-content/uploads/2021/06/libro-terapia-fotodinamica.jpg
214
342
s6YbpV4uzUeY7BN3
http://alphastrumenti.com/wp-content/uploads/2017/08/logo-1-300x128.png
s6YbpV4uzUeY7BN32021-06-16 14:05:282021-06-16 14:06:56Malattie dermatologiche rare: i benefici terapeutici della luce https://alphastrumenti.com/wp-content/uploads/2021/04/upmc-italy_webinar-ECM-di-Dermatologia-300x300-1.jpg
300
300
s6YbpV4uzUeY7BN3
http://alphastrumenti.com/wp-content/uploads/2017/08/logo-1-300x128.png
s6YbpV4uzUeY7BN32021-04-17 08:24:302021-04-17 08:25:00UPMC Academy in Italy – webinar ECM di Dermatologia
https://alphastrumenti.com/wp-content/uploads/2021/04/upmc-italy_webinar-ECM-di-Dermatologia-300x300-1.jpg
300
300
s6YbpV4uzUeY7BN3
http://alphastrumenti.com/wp-content/uploads/2017/08/logo-1-300x128.png
s6YbpV4uzUeY7BN32021-04-17 08:24:302021-04-17 08:25:00UPMC Academy in Italy – webinar ECM di Dermatologia https://alphastrumenti.com/wp-content/uploads/2021/02/9788831222624_0_221_0_75.jpg
324
221
s6YbpV4uzUeY7BN3
http://alphastrumenti.com/wp-content/uploads/2017/08/logo-1-300x128.png
s6YbpV4uzUeY7BN32021-02-22 13:49:592021-02-22 13:50:22La Terapia Fotodinamica nelle malattie dermatologiche rare
https://alphastrumenti.com/wp-content/uploads/2021/02/9788831222624_0_221_0_75.jpg
324
221
s6YbpV4uzUeY7BN3
http://alphastrumenti.com/wp-content/uploads/2017/08/logo-1-300x128.png
s6YbpV4uzUeY7BN32021-02-22 13:49:592021-02-22 13:50:22La Terapia Fotodinamica nelle malattie dermatologiche rare https://alphastrumenti.com/wp-content/uploads/2020/07/img-134537-O-29-903-0-0-15896ecfa8158447cd89ac9700d65d3a.jpg
900
1600
s6YbpV4uzUeY7BN3
http://alphastrumenti.com/wp-content/uploads/2017/08/logo-1-300x128.png
s6YbpV4uzUeY7BN32020-07-08 16:36:472020-07-08 16:36:47Covid-19 News – Test sierologici e storia anamnestica in: pazienti che sono stati sintomatici o paucisintomatici; pazienti che sono sempre stati asintomatici. Suggerimenti per un corretto approccio clinico.
https://alphastrumenti.com/wp-content/uploads/2020/07/img-134537-O-29-903-0-0-15896ecfa8158447cd89ac9700d65d3a.jpg
900
1600
s6YbpV4uzUeY7BN3
http://alphastrumenti.com/wp-content/uploads/2017/08/logo-1-300x128.png
s6YbpV4uzUeY7BN32020-07-08 16:36:472020-07-08 16:36:47Covid-19 News – Test sierologici e storia anamnestica in: pazienti che sono stati sintomatici o paucisintomatici; pazienti che sono sempre stati asintomatici. Suggerimenti per un corretto approccio clinico. https://alphastrumenti.com/wp-content/uploads/2020/06/terapia-fotodinamica-2.jpg
800
1920
s6YbpV4uzUeY7BN3
http://alphastrumenti.com/wp-content/uploads/2017/08/logo-1-300x128.png
s6YbpV4uzUeY7BN32020-06-19 10:00:402020-06-19 10:02:51Una sfida terapeutica di tipo biologico per le ulcere croniche: risultati di uno studio clinico pilota
https://alphastrumenti.com/wp-content/uploads/2020/06/terapia-fotodinamica-2.jpg
800
1920
s6YbpV4uzUeY7BN3
http://alphastrumenti.com/wp-content/uploads/2017/08/logo-1-300x128.png
s6YbpV4uzUeY7BN32020-06-19 10:00:402020-06-19 10:02:51Una sfida terapeutica di tipo biologico per le ulcere croniche: risultati di uno studio clinico pilota https://alphastrumenti.com/wp-content/uploads/2020/05/ozone_meter_02.jpg
524
660
Francoalphastru
http://alphastrumenti.com/wp-content/uploads/2017/08/logo-1-300x128.png
Francoalphastru2020-05-09 15:42:132020-05-09 15:42:13Misurare la presenza di ozono nell’ambiente.
https://alphastrumenti.com/wp-content/uploads/2020/05/ozone_meter_02.jpg
524
660
Francoalphastru
http://alphastrumenti.com/wp-content/uploads/2017/08/logo-1-300x128.png
Francoalphastru2020-05-09 15:42:132020-05-09 15:42:13Misurare la presenza di ozono nell’ambiente. https://alphastrumenti.com/wp-content/uploads/2018/07/lasponda.png
600
600
s6YbpV4uzUeY7BN3
http://alphastrumenti.com/wp-content/uploads/2017/08/logo-1-300x128.png
s6YbpV4uzUeY7BN32018-07-23 14:26:202018-07-23 14:33:0736° Premio Internazionale FONTANE di ROMA
https://alphastrumenti.com/wp-content/uploads/2018/07/lasponda.png
600
600
s6YbpV4uzUeY7BN3
http://alphastrumenti.com/wp-content/uploads/2017/08/logo-1-300x128.png
s6YbpV4uzUeY7BN32018-07-23 14:26:202018-07-23 14:33:0736° Premio Internazionale FONTANE di ROMA https://alphastrumenti.com/wp-content/uploads/2017/08/buona-476-x-600.jpg
600
476
s6YbpV4uzUeY7BN3
http://alphastrumenti.com/wp-content/uploads/2017/08/logo-1-300x128.png
s6YbpV4uzUeY7BN32017-08-25 16:05:492017-08-28 07:21:47LE CICATRICI TRATTATE CON DERMAROLLER
https://alphastrumenti.com/wp-content/uploads/2017/08/buona-476-x-600.jpg
600
476
s6YbpV4uzUeY7BN3
http://alphastrumenti.com/wp-content/uploads/2017/08/logo-1-300x128.png
s6YbpV4uzUeY7BN32017-08-25 16:05:492017-08-28 07:21:47LE CICATRICI TRATTATE CON DERMAROLLER https://alphastrumenti.com/wp-content/uploads/2017/08/ART_1518.jpg
450
600
s6YbpV4uzUeY7BN3
http://alphastrumenti.com/wp-content/uploads/2017/08/logo-1-300x128.png
s6YbpV4uzUeY7BN32017-08-25 16:04:182017-08-25 16:04:18PDT ACIDO 5-AMINOLEVULINICO
https://alphastrumenti.com/wp-content/uploads/2017/08/ART_1518.jpg
450
600
s6YbpV4uzUeY7BN3
http://alphastrumenti.com/wp-content/uploads/2017/08/logo-1-300x128.png
s6YbpV4uzUeY7BN32017-08-25 16:04:182017-08-25 16:04:18PDT ACIDO 5-AMINOLEVULINICO https://alphastrumenti.com/wp-content/uploads/2017/08/foto40-1-1.png
506
900
s6YbpV4uzUeY7BN3
http://alphastrumenti.com/wp-content/uploads/2017/08/logo-1-300x128.png
s6YbpV4uzUeY7BN32017-08-25 16:00:392017-08-25 16:00:39LA LUCE DI WOOD IN VERSIONE MINIATURIZZATA
https://alphastrumenti.com/wp-content/uploads/2017/08/foto40-1-1.png
506
900
s6YbpV4uzUeY7BN3
http://alphastrumenti.com/wp-content/uploads/2017/08/logo-1-300x128.png
s6YbpV4uzUeY7BN32017-08-25 16:00:392017-08-25 16:00:39LA LUCE DI WOOD IN VERSIONE MINIATURIZZATAAlphaStrumenti Srl
Via Volontari del Sangue 4
20066 Melzo – MI –
P.iva 06754120159
______________________
MENU
CONTATTI
email: info@alphastrumenti.com
tel: +39.0295738540
fax: +39.029551815













